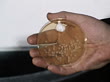
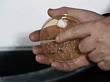

A hand holds a petri dish containing penicillin bacteria. 1978.
A hand holds a petri dish containing penicillin bacteria. 1978. (Core Number: ANBA318D)

PURCHASE A LICENSE
Get personalized pricing by telling us when, where, and how you want to use this asset.
DETAILS
Restrictions:
No use as a complete program, for sequential use with other BBC clips, for unofficial association with BBC, or in a manner that brings BBC into disrepute. Additional BBC Motion Gallery restrictions apply – see Section 3(g) of applicable Getty Images license agreement. Please contact Getty Images for any use of this clip for education/learning purposes.
Editorial #:
1B011815_0008
Collection:
BBC Editorial
Date created:
November 14, 1978
Upload date:
License type:
Rights-ready
Release info:
Not released.ÌýMore information
Clip length:
00:00:09:10
Location:
United Kingdom
Mastered to:
QuickTime 8-bit Photo-JPEG SD 720x576 25p
Source:
BBC Editorial
Object name:
AEXZ288W
- Antibiotic Videos,
- Penicillin Videos,
- 1970-1979 Videos,
- Alexander Fleming Videos,
- Archival Videos,
- Bacterium Videos,
- Color Image Videos,
- England Videos,
- Fungal Mold Videos,
- Fungus Videos,
- Hand Videos,
- Inside Of Videos,
- Petri Dish Videos,
- Raw Footage Videos,
- Real Time Video Videos,
- Science and Technology Videos,
- UK Videos,